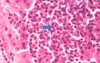

Liver Disease in SA Flashcards
(47 cards)
Evaluation of the Liver
(3)
- can look at these different aspects and any changes

Enzymes Indicating Hepatocellular Damage
(4)
- these are the classic ones- leakage enzymes
- tell us there is damage to the hepatocytes

Hepatocellular damage - “leakage”
- these enzymes are readily available from the cytosol of the hepatocytes
- if there is damage to hepatocytes and it dies, the enzymes in hte cytoplasm will be released
- or some degree of damage to hepatocyte causes wall to release a little bit of cytoplasmic material
- blebosome: will have a bit of cytoplasmic material in it
- if you even just have a lot of blebbing from a large amount of hepatocytes, will still see an increase of these specific enzymes

Hepatocellular Enzymes: ALT and GLDH
- will increase about 12 hours after injury
- last for about 1-2 days
- more common in SA
large animals: ALT activity is very low!
*

Hepatocellular Enzymes: AST and ALT
- if you have marked muslce damage, you may see increase in AST
- need to differentiate if it is liver damage or liver damage
- CCK can help in this
- (echo)
- need to factor in how specific certain enzymes are to a tissue

Liver vs. Muscle
- CK can be a good indicator of muscle cell damge, but has a very short half life
- so the measurement of this parallel is not full proof

Enzymes Indicating Cholestasis
(2)
- we have lots and lots of hepatocytes, can see increases with little or large damage
- key enzymes of cholestasis: ALP and GGT
*

Alkaline Phosphatase
(ALP)
Derived from bile duct epithelium
- cholestasis will irritate bile duct epithelial cells and this ALP will be released
- but it also comes from other places too (young dogs- bone isoform of ALP) –> need to be aware
- any dog that is stressed or given prednisolone over time will likely have a notable ALP increase (steroid induced isoform)
- in cats it has a VERY short half life, any increase is significant (could be hepatic lipidosis, or if not yellow- hyperthyroidism) –> the dynamic of the changes can be very important in cats
- dogs can get an increase for stress and other things

Induction vs. Leakage
ALP is an induction enzyme: they are present on some of the biliary epithelium but can also have induced production of these enzymes –> trascription and translation induced
- different to the leakage enzymes which are present in the cytoplasm
- may see these enzymes 6 or 7 days later after the induction process occurs and then are released –> ex: steroid induced

Gammaglutamyltransferase (GGT)
- other cholestetic enzyme we look at
- nursing animals will have a high GGT as it is in colostrum
- If renal tubular cells get damaged, they will release this into the urine, BUT NOT THE BLOOD, need to be aware

Measures of Hepatic Function
(7)
- key enzymes
- leakage: dmaage to hepatocytes
- cholestasis: blockage present
- these are generally on biochem panel
- these are measure of liver FUNCTION where as other enzymes show damage
- can have damage but the functional capacity of the liver is rather large
- damage and function of the hepatocyte does not have to coincide but can also go hand in hand

Bilirubin Metabolism
- we have a regular turnover of RBC’s (110 days) and we want to conserve ironand conserve Hb –>happening in spleen
- bilirubin is not solube in water- trafficked using albumin
- conjugated in the hepatocyte –> makes it water soluble (can then float in fluid without carrier)
- conjugated bilrubin will be converted urobilin or stercobilin or can be excreted in the urine
- WATCH THE VIDEO

Bilirubin

Bilirubinemia- Hemolysis
- if you have excess break down of RBC’s
- the hepatocytes can only conjugate so much
- the key limiting step though is the EXCRETION INTO THE BILE
- there will be back up into the system, you will start to leak out the conjugated bilirubin which is soluble and you will see it being released in urine

Bilirubinemia - Cholestasis
- Break down of RBCs is normal, the hepatocytes will conjugate the bilirubin
- there is blockage: bilirubin in the blood and in the urine

Bilirubinuria

Ammonia and Urea
(what is ammonia converted into?)
- when you eat a proteinaceous meal, there is ammonia present and will be detoxified in the liver into urea (still toxic but not as toxic) and then can excrete urea into the kidneys
- If you have a filing liver, you will have a decrease in urea in the blood
- ammonium will increase

Ammonia and Urea
(role of urea and what is seen in hepatic disease?)
- bilirubin will increase in the blood if the liver is failing because the liver cant process it and get it into the biliary ducts
*

Glucose
- If the liver is fialing you may see a decrease in glucose as the liver cant synthesize it
- but glucose is so important that this is not an early sign as it is conserved until desparate
- failing liver–> would see decrease in albumin

Cholesterol
(synthesis and increase/decrease)

Cholesterol
- If the liver fails to build cholesterol, it will go down in the blood
- If there is blockage there may be an increase
- or you can have both happening and not really see a change (could still be liver failure)
- essentially cholesterol levels are not PARTICULARLY helpful
- post prandial- post meal (be aware of cholesterol increase there)
*

BIle Acids
- echo
- why do we need bile acids? emulsify fat in digestion, need to have it coming into the gut
- liver builds bile acids and excretes into bile ducts, but it is expensive to build bile acid!
- NEED TO RECYCLE
once bile does its job, it is reabsorbed by portal vein and is taken up by hepatocytes to be excreted again - in healthy animal: should see bile acids in duct or bile
- but shouldnt see in circulation!

BIle Acid Concentration [BA]
- want to feed the animal after initial reading
- will cause the gall bladder to contract, can see if the liver is not uptaking the bile acid correctly

increase [BA] in serum or plasma
- either a decrease in clearance from portal blood or lower excretion via bile
- portosystemic shunt: abnormal vessel that connects the portal blood to a vessel –> can be congenital or acquired (hepatocytes are functioning well but the blood might be channeled away from the hepatocyte)
- Obstructive cholestasis: bile acids cannot be excreted (backed up toilet effect)
- If bilirubin is high due to cholestasis then you know bile acids are high, but only do the bile acid test when necessary (if they arent really icteric)